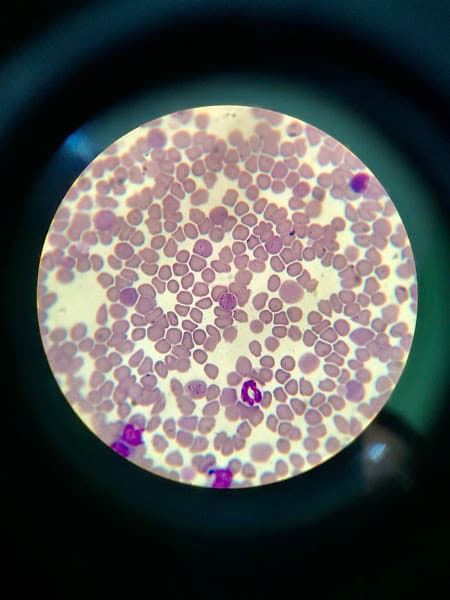
Hình ảnh Bệnh Viện Thú Y OKADA Pet Hospital - 2

Bác sỹ giỏi, thân thiện. Vệ sinh sạch sẽ. Giá cả hợp lý. Tôn trọng khách hàng
Chạy quảng cáo khen nhiều nhưng đội ngũ nhân viên thiếu kinh nghiệm, thiếu trách nhiệm làm chết chó của tôi, chó của tôi bị chết cứng ngắt nhưng nhân viên cố tình thông báo muộn đến khi chó chết cứng rồi mới gọi người về nhận xác, sau đó thì tôi biết chỉ tắm và sấy bằng đèn rồi xét nghiệm máu thì bảo thiếu máu nên tôi đã đem luôn chó ở nhà đến để xét nghiệm xem có cùng nhóm máu không, thì nhân viên bảo ko cùng nhóm máu. Tổng chi phí xét nghiệm máu đó gần 1 triệu. Sau cả 1 tiếng thì NV mới gọi đth thông báo về nhận xác, tôi có phản ánh lên bác sĩ Hải thì bác bảo có gọi về NV hỏi thì nhân viên nói do tôi đến chậm cả tiếng nên chó chết cứng? Trong khi nhà tôi gần bệnh viện này? Lúc đưa chó đến tôi muốn vào xem tình hình thì NV ko cho vào nên tôi mới về nhà đợi. Có lẽ NV đã cố tình nói láo với bác sĩ Hải để chối bỏ trách nhiệm. Trước đó chó tôi ở nhà vẫn đi lại bình thường chỉ có mệt và bỏ ăn thôi, mai lại tôi đem chó đến bệnh viện này thì nghe tin chó chết liền, không thể mà chết nhanh như vậy đc. Chỉ có đội ngũ thiếu kinh nghiệm trách nhiệm. Khuyên mn không nên đến bệnh viện này nếu ko muốn chó của mình chết và bị chối bỏ đổ thừa lỗi do mình
bệnh viện lừa người khác, mèo nhà mình đang trong nguy kịch mình đưa đến vào ban đêm nên không mở cửa nên mình gọi cho số cấp cứu ở biển nhỏ bên ngoài khi đầu kia bắt máy mình có nói sơ về tình hình hiện tại của bé thì đầu kia nói không phải bác sĩ không biết cấp cứu gì hết rồi cúp máy ngang sau đó thì ai cũng đoán được tình trạng của bé mèo (trong khi bé có thể cứu được ) mong bệnh viện điều chỉnh lại cách làm ăn của mình để có thể cứu sống các bé khác còn không làm được thì dẹp bệnh viện đi đừng tạo nghiệp
Vắc xin tốt, thái độ của nhân viên tận tình, phòng khám sạch sẽ
Bệnh viện làm ko có lương tâm chích 2 mũi thuốc về chó chết luôn điện nói chuyện ko đàng hoàng tắt ngang nữa chừng khuyến cáo mọi người ko nên tới bệnh viện này xin cảm ơn